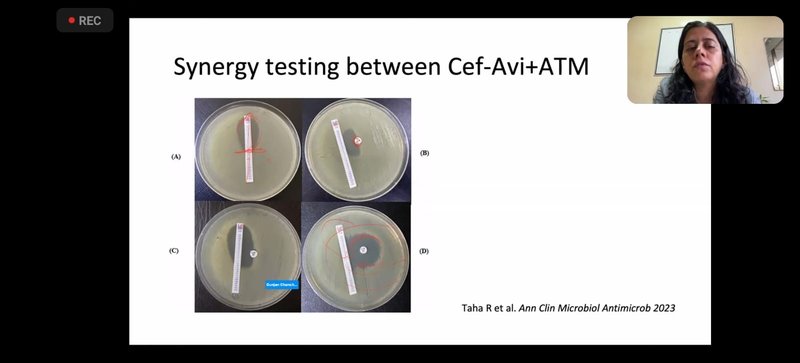
IMG-20241119-WA0074

Webinar was conducted by Critical Care Medicine Dept .The Speaker Dr Gunjan Chanchalani , Chief Intensivist , K J Somaiya Hospital ,Mumbai, gave a very good lecture on practical aspects of Gram negative infections.The lecture covered GNBs - Mechanism of resistance, Beta lactamase classification, synergy testing between various antibiotic combinations, comparison between Colistin and Polymyxin B, Treatment of MDR GNB, Carbapenem resistant Pseudomonas Aeruginosa (CRPA), Carbapenem resistant Acinetobacter baumanii(CRAB), Newer Drugs : Ceftazidime+ Avibactam, Ceftolozane /tazobactum , meropenem/ Vaborbactam, Imipenem/ Cilastin/Relebactam , Cefiderocol , Plazomicin. The lecture was very informative and practically useful in dealing with multidrug resistant infections in Critical Care Unit.
The Webinar was attended by:
Dr Shilpa Patil ,HOD CCM,
Dr Ajinkya Bahulekar , Associate Professor CCM,
Dr Vaibhav Tulsyan , Assistant Professor CCM,
DM CCM Senior residents : Dr Kamal, Dr Yashwanth, Dr Smith , Dr Naveen.